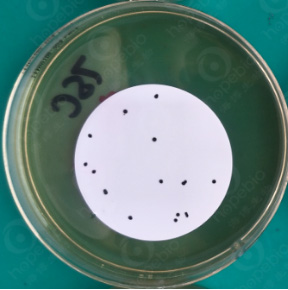

一、试验原理:
胰胨-亚硫酸盐-环丝氨酸琼脂培养基(TSC)用于产气荚膜梭菌的平板计数。胰胨、大豆胨和酵母浸粉作为培养基中的基础营养物质,提供细菌生长所需的碳氮源、维生素和其他的生长因子;的产生,产气荚膜梭菌能利用焦亚硫酸钠中的S产生硫化氢气体,与柠檬酸铁铵中的亚铁离子反应生成黑色的硫化亚铁物质;D-环丝氨酸能抑制革兰氏阴性菌和其他非梭菌细菌的生长;琼脂是培养基的凝固剂。
二、培养基配方(g/L):
|
胰胨 大豆胨 酵母浸粉 柠檬酸铁铵 焦亚硫酸钠 琼脂 pH值7.6±0.2(25℃) |
15.0 5.0 5.0 1.0 1.0 15.0
|
三、试验方法:
1)称取本品47.0g,加热溶解于1000mL蒸馏水中,分装三角瓶,121℃高压灭菌15分钟,冷却至50℃时,每250mL培养基加入过滤除菌的0.5% D-环丝氨酸溶液20mL,混匀,备用。
2)采用滤膜法,取50mL的水样用孔径为0.45μm的滤膜过滤,然后将滤膜移至TSC琼脂培养基上,倒置于36℃±1℃厌氧培养24h,计数黑色菌落。
四、试验结果判断:
接种以下质控菌株,放置36±1℃需氧培养22-24小时。
|
质控菌株 |
菌株编号 |
接种量(CFU) |
方法 |
质控结果 |
其他特征 |
|
产气荚膜梭菌 |
ATCC 13124 |
20-200 |
定量 |
PR≥0.7 |
黑色菌落 |
|
艰难梭菌 |
ATCC 43593 |
/ |
半定量 |
G≤1 |
/ |
产气荚膜梭菌ATCC13124
上一篇:乳糖发酵培养基实验原理及实验结果
下一篇:KF链球菌琼脂原理和使用方法

传真:0532-81935080 66087775
邮箱:qdhbywg@vip.126.com
QQ:4000532596